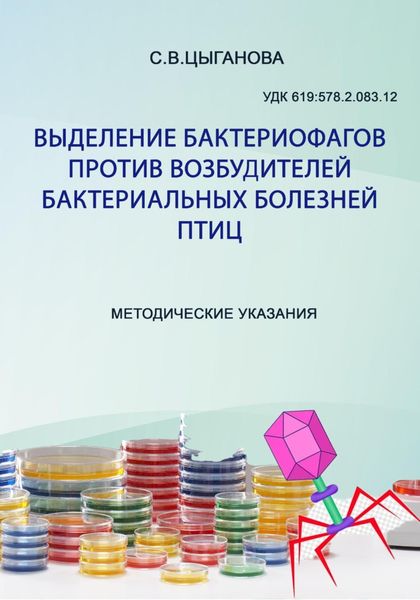
Выделение бактериофагов против возбудителей бактериальных болезней птиц. Методические рекомендации

Книги жанра «Образование»

Отношения РФ и НАТО в контексте проблемы обеспечения европейской безопасности в 1991-2021 гг
Евгений Викторович Семибратов

Теоретические основы криминологического анализа и предупреждения демонстративно-протестной преступности
Илья Сергеевич Ильин
Выделение бактериофагов против возбудителей бактериальных болезней птиц. Методические рекомендации
Светлана Вячеславовна Цыганова

Практическое руководство по конному спорту. Том 1. Начальная подготовка всадника и лошади
Christoph Hess

Организационно-методические вопросы управления закупками на предприятиях промышленности. Монография
Вячеслав Игоревич Плещенко



















